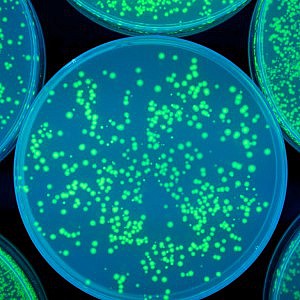

- News
News and Updates
Stay informed with Maulin Law.
Explore the latest news, insights, and updates from the world of medical malpractice defence. From case law developments to innovative defence strategies, we keep you informed with valuable content tailored to insurers, healthcare providers, and professionals.
Filter
- News
- Sector insights
- News
- News
- Sector insights
- Sector insights